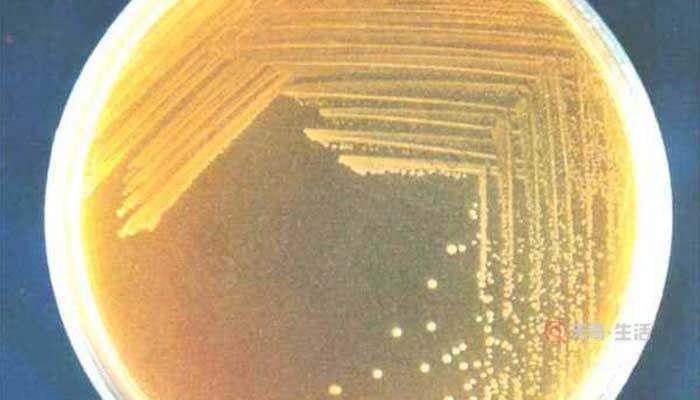

大小区别:细菌菌落一般较小,甚至是比较不起眼的;而真菌菌落明显会比细菌菌落大。颜色区别:细菌菌落的颜色一般都比较淡和浅,多为白色、透明色、黄色;真菌菌落颜多且较深,常见的颜色有绿、黑、褐、黄、绿色等。形态区别:细菌菌落表面光滑或粗糙,而真菌菌落的形状各式各样。

细菌菌落和真菌菌落的区别是什么
细菌菌落是肉眼可见的菌块,每一种细菌在一定条件下形成固定的菌落特征,不同种或同种在不同的培养条件下,其菌落特征是不同的。同样的,真菌菌落也是肉眼可见的真菌菌落,和细菌菌落有着明显的区别,如下;
1、大小方面
细菌菌落一般较小,甚至是比较不起眼的;但真菌菌落,特别是霉菌落落是比较大的,非常的显眼的大小的对比。两种菌落可以肉眼分辨谁是细菌菌落和真菌菌落。
2、颜色方面
细菌菌落一般是白色、透明色、黄色等,且基本上是比较淡和浅的颜色。真菌菌落的颜色是多种多样的,常见的有绿、黑、褐、黄、绿色。例如:霉菌菌落最常见颜色是绿色和黑色。
3、形态方面
细菌菌落的表面要么是光滑黏稠,要么是粗燥干燥的,十分有特色,很容易分辨。真菌菌落的形状各式各样,有蜘蛛网状的,有絮状的,还有绒毛样子的。
版权声明:本文内容由互联网用户自发贡献,该文观点仅代表作者本人。本站仅提供信息存储空间服务,不拥有所有权,不承担相关法律责任。如发现本站有涉嫌抄袭侵权/违法违规的内容, 请发送邮件至 1543321114@qq.com 举报,一经查实,本站将立刻删除。